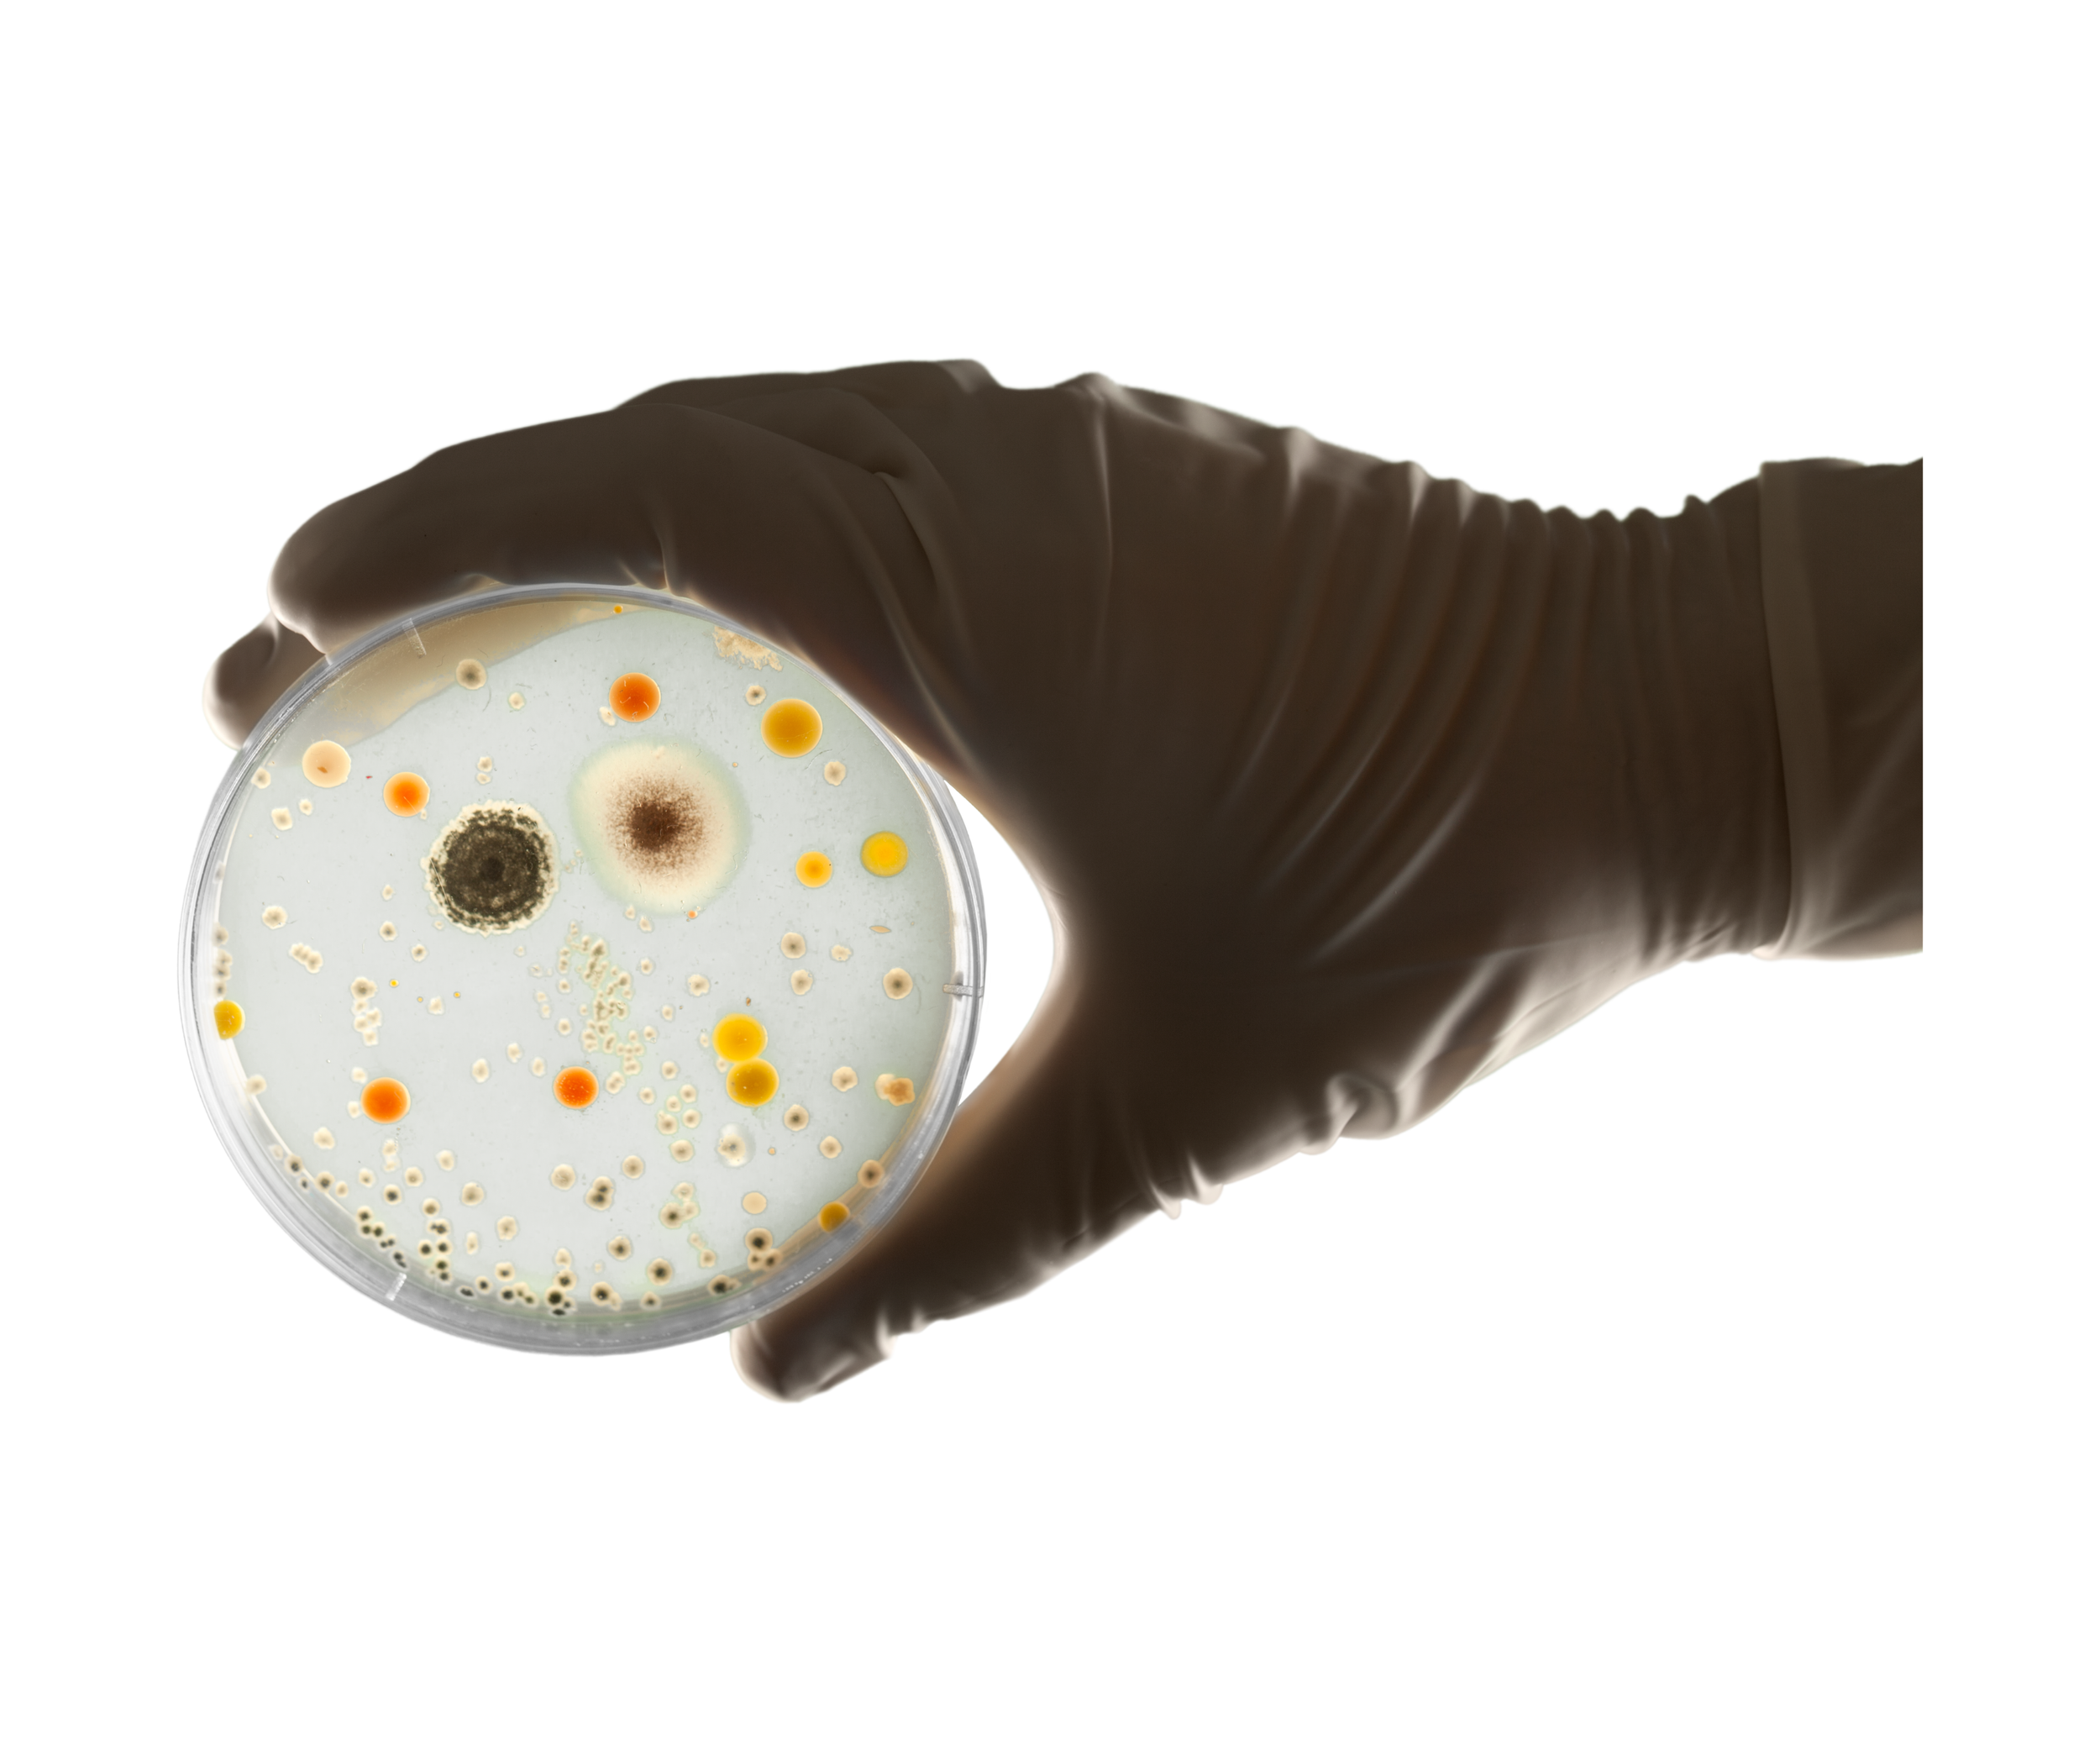

Protección Profesional, Calidad Garantizada
Protección Profesional, Calidad Garantizada
¡Bienvenido a Spartan Sanidad Ambiental!
En Spartan, nos dedicamos a proporcionar servicios profesionales de control de plagas y fumigación para garantizar entornos limpios, seguros y saludables. Con una amplia experiencia y un enfoque centrado en la calidad y la seguridad, ofrecemos soluciones efectivas y personalizadas para abordar una variedad de problemas de plagas.
Desde la eliminación de insectos molestos hasta el control de roedores no deseados, nuestro equipo altamente capacitado utiliza técnicas avanzadas y productos ecológicos para brindar resultados duraderos sin comprometer la salud de las personas ni el medio ambiente.
PLAGAS COMUNES EN MEXICALI
Servicio para insectos rastreros y voladores (Cucarachas, hormigas, moscas, mosquitos etc.)
En Spartan Sanidad Ambiental, ofrecemos un servicio integral y altamente efectivo para el control de insectos rastreros y voladores. Nuestro enfoque está diseñado para proporcionar soluciones duraderas y seguras, protegiendo su hogar, negocio o industria de las amenazas que representan estos insectos. A continuación, se detalla el proceso que realizamos:
1. Inspección Inicial
Evaluación del Sitio: Realizamos una inspección exhaustiva de la propiedad para identificar las áreas problemáticas y los signos de infestación, como presencia de insectos, huevos y daños estructurales.
Identificación de Especies: Determinamos las especies de insectos presentes, lo que nos permite adaptar nuestras estrategias de control a las características específicas de cada tipo de insecto.
2. Implementación de Medidas de Control
Aspersión de Baja Presión: Aplicamos insecticidas de baja presión en áreas específicas para un control localizado y efectivo de insectos rastreros y voladores.
Aspersión de Alta Presión: Utilizamos aspersores de alta presión para cubrir grandes áreas y asegurar una aplicación uniforme y extensa de los productos de control.
Espolvoreo: Aplicamos polvos insecticidas en áreas de difícil acceso para asegurar la eliminación completa de los insectos.
Nebulización Fría: Utilizamos técnicas de nebulización fría para generar una niebla fina que penetra en todos los rincones, controlando eficazmente insectos voladores como mosquitos y moscas.
Termonebulización: Empleamos la termonebulización para generar una niebla caliente que se infiltra en áreas inaccesibles, garantizando un control profundo y efectivo de los insectos.
Aplicación de Humo: En áreas cerradas y de difícil acceso, utilizamos la aplicación de humo para asegurar la eliminación de los insectos presentes.
3. Monitoreo y Seguimiento
Revisiones Periódicas: Realizamos visitas periódicas para monitorear la efectividad del tratamiento, detectar posibles reapariciones y ajustar las medidas de control según sea necesario.
Informes Detallados: Proporcionamos informes detallados de cada visita, incluyendo las acciones realizadas, los resultados obtenidos y recomendaciones adicionales para mantener la propiedad libre de insectos.
4. Prevención a Largo Plazo
Educación al Cliente: Ofrecemos asesoramiento sobre prácticas preventivas y medidas de higiene que pueden adoptar para minimizar el riesgo de futuras infestaciones.
Mantenimiento Preventivo: Proponemos un programa de mantenimiento preventivo adaptado a las necesidades específicas del cliente, asegurando un control continuo y efectivo de insectos.
Servicio para roedores
En Spartan Sanidad Ambiental, ofrecemos un servicio integral y profesional de control de roedores, diseñado para proteger su hogar, negocio o industria de las amenazas que representan las ratas y los ratones. Nuestro enfoque combina la inspección detallada, la implementación de soluciones efectivas y la prevención a largo plazo. A continuación, se detalla el proceso que realizamos:
1. Inspección Inicial
Evaluación del Sitio: Realizamos una inspección exhaustiva de la propiedad para identificar signos de infestación, como excrementos, huellas, madrigueras y daños estructurales.
Identificación de Especies: Determinamos las especies de roedores presentes, lo que nos permite adaptar nuestras estrategias de control a las características específicas de cada tipo de roedor.
2. Implementación de Medidas de Control
Trampas y Estaciones de Cebo: Instalamos trampas y estaciones de cebo en puntos estratégicos para capturar y eliminar roedores. Utilizamos productos seguros y efectivos, asegurándonos de minimizar cualquier riesgo para personas y mascotas.
Barreras Físicas: Le indicamos en que lugares debe sellar y reforzar puntos de entrada potenciales para evitar la entrada de roedores a la propiedad. Esto incluye la reparación de grietas, agujeros y cualquier otra abertura que puedan utilizar.
Aplicación de Rodenticidas: En casos necesarios, aplicamos rodenticidas en áreas específicas para garantizar la eliminación completa de la infestación. Estos productos son seleccionados y aplicados de acuerdo con las normativas de seguridad y salud vigentes.
3. Monitoreo y Seguimiento
Revisiones Periódicas: Realizamos visitas periódicas para revisar y reponer trampas y estaciones de cebo, asegurándonos de que la infestación esté controlada y previniendo posibles reapariciones.
Informes Detallados: Proporcionamos informes detallados de cada visita, incluyendo las acciones realizadas, los resultados obtenidos y recomendaciones adicionales para mantener la propiedad libre de roedores.
4. Prevención a Largo Plazo
Educación al Cliente: Ofrecemos asesoramiento sobre prácticas preventivas y medidas de higiene que pueden adoptar para minimizar el riesgo de futuras infestaciones.
Mantenimiento Preventivo: Proponemos un programa de mantenimiento preventivo adaptado a las necesidades específicas del cliente, asegurando un control continuo y efectivo de roedores.
Servicio de desinfección
En Spartan Sanidad Ambiental, ofrecemos un servicio de desinfección integral y profesional, diseñado para proporcionar un entorno seguro y saludable para hogares, negocios e industrias. Utilizamos métodos avanzados y productos de alta calidad para eliminar eficazmente bacterias, virus y otros microorganismos nocivos. A continuación, se detalla el proceso que realizamos:
1. Inspección Inicial
Evaluación del Sitio: Realizamos una inspección exhaustiva de la propiedad para identificar las áreas críticas y de alto riesgo que requieren desinfección.
Detección de Contaminantes: Determinamos la presencia y tipo de microorganismos que pueden estar afectando el área, permitiéndonos seleccionar los productos y métodos más adecuados.
2. Implementación de Medidas de Desinfección
Preparación del Área: Preparamos el área para la desinfección, asegurando que todos los objetos y superficies estén accesibles y listos para el tratamiento.
Selección de Productos: Utilizamos productos desinfectantes certificados y de alta eficacia, seleccionados específicamente para combatir los microorganismos identificados.
Métodos de Aplicación:
Aspersión de Baja Presión: Aplicamos desinfectantes en áreas específicas con aspersores de baja presión para un control localizado.
Nebulización Fría: Utilizamos técnicas de nebulización fría para generar una niebla fina que penetra en todos los rincones, asegurando una desinfección completa de superficies y ambientes.
Termonebulización: Empleamos la termonebulización para generar una niebla caliente que se infiltra en áreas inaccesibles, proporcionando una desinfección profunda y efectiva.
Aplicación de Humo: En áreas cerradas y de difícil acceso, utilizamos la aplicación de humo para asegurar la eliminación de microorganismos presentes.
3. Monitoreo y Seguimiento
Revisiones Periódicas: Realizamos visitas periódicas para monitorear la efectividad del tratamiento, verificar la ausencia de microorganismos y ajustar las medidas de desinfección según sea necesario.
Informes Detallados: Proporcionamos informes detallados de cada visita, incluyendo las acciones realizadas, los resultados obtenidos y recomendaciones adicionales para mantener la propiedad desinfectada.
4. Prevención a Largo Plazo
Educación al Cliente: Ofrecemos asesoramiento sobre prácticas preventivas y medidas de higiene que pueden adoptar para minimizar el riesgo de futuras contaminaciones.
Mantenimiento Preventivo: Proponemos un programa de mantenimiento preventivo adaptado a las necesidades específicas del cliente, asegurando una desinfección continua y efectiva.